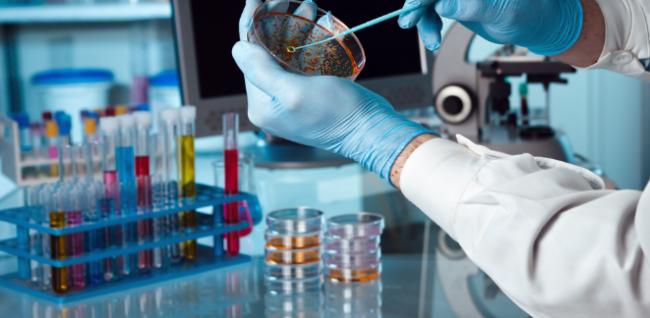
Descendieron los casos en la última semana

El proyecto pasó al Senado en revisión
La Cámara de Diputados aprobó la suspensión de las PASO
23/08/2022. La cámara baja aprobó suspender las Primarias Abiertas Simultáneas y Obligatorias del año 2023.
23/08/2022. La cámara baja aprobó suspender las Primarias Abiertas Simultáneas y Obligatorias del año 2023.
23/08/2022. El acto de juramento del Defensor General de la Provincia se llevará a cabo el jueves 25 de agosto.
23/08/2022. Continúa la ejecución de obras de infraestructura en San Luis, sobre la ruta Nacional N° 51. Los trabajos tienen una inversión de más de 70 millones de pesos.
23/08/2022. En ocasiones, por unos minutos, se interrumpirá el tránsito para realizar los trabajos. Se solicita circular con precaución y paciencia por esta zona de la ruta 28.
23/08/2022. La Cámara baja analizará en su sesión de este martes el proyecto de Ley por el cual se suspenden las PASO provinciales para el año próximo.
22/08/2022. En sesión especial el cuerpo aprobó la expulsión del edil Ricardo Colque. Se aclaró que la decisión no implica una valoración judicial del caso.
22/08/2022. Se trata de instituciones educativas de las localidades de Los Andes, San Carlos y La Poma. El ciclo lectivo de este régimen termina el 31 de mayo del 2023.
22/08/2022. En la semana epidemiológica 33 -comprendida entre el 14 y el 20 de agosto- se notificaron 432 casos nuevos en la provincia, todos confirmados por laboratorio.
22/08/2022. Se inscribirá hasta el jueves 25. Los interesados mayores de 16 años podrán registrarse presentando DNI en el edificio del Dispositivo Territorial Comunitario de San Benito, de 9 a 18. La primera clase será este viernes y será sobre Robótica.
22/08/2022. “Producto de la articulación público-privada del Gobierno de Salta y de la Fundación Siwok, el invernadero de Misión La Paz ya cumple su objetivo de multiplicar la producción local de hortalizas, permitiendo mejorar la nutrición de los habitantes de la comunidad wichí y dando lugar inclusive a la comercialización”, expresó con satisfacción el funcionario al ver los frutos de la primera plantación de tomates que se hizo en la zona y que actualmente transita su segunda temporada.
19/08/2022. Financia el 80% de las inversiones de capital de trabajo comercial, por un monto máximo de hasta un $1 millón, según el promedio de facturación mensual. Los plazos para devolución son 30, 60 y 90 días corridos.
19/08/2022. Nación, provincias y municipios realizarán este sábado la edición 21 de Alcoholemia Federal. Serán miles de operativos en simultáneo para controlar y evitar que conductores transiten por la vía pública bajo los efectos del alcohol.